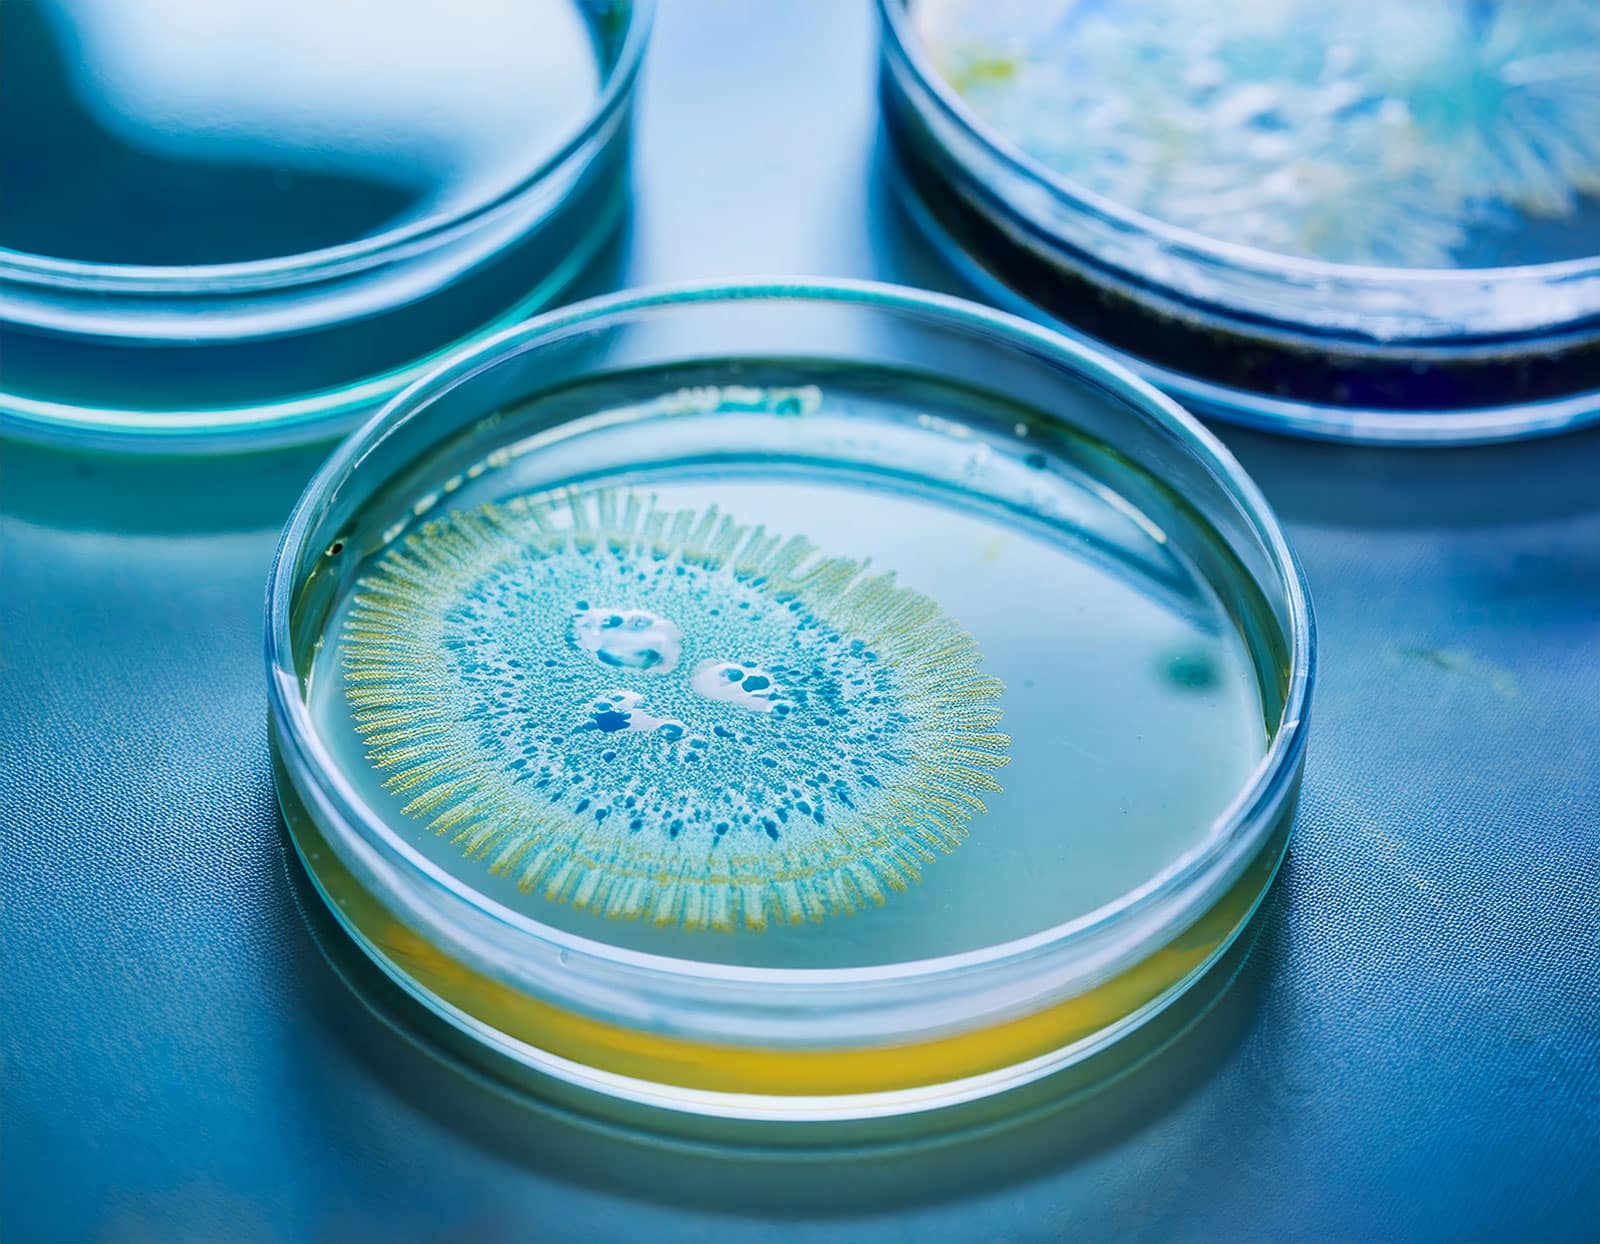
Can You Drink While on Amoxicillin? - Illinois Recovery Center

What Happens When You Drink On Amoxicillin

So, you've been prescribed Amoxicillin. Yay! You're on your way to kicking that pesky infection to the curb. Your doctor probably gave you a whole spiel about taking it regularly, finishing the course, and generally being a responsible patient. But then, the age-old question pops into your head, whispered by the devil on your shoulder (or maybe just your best friend after a few happy hour drinks): "Can I have a little fun while I'm on this stuff?"
Let's be honest, the thought has probably crossed your mind. You're feeling a bit better, the worst is over, and suddenly that social gathering or that cozy night in with a glass of your favorite beverage seems incredibly tempting. It's like your body is saying, "Hey, I'm healing! Let's celebrate!" But then that little voice of reason (or maybe just fear of side effects) chimes in.
The official line from your doctor and the little leaflet inside your pill packet is pretty clear. They'll likely tell you something along the lines of, "Avoid alcohol while taking Amoxicillin." They might even give you a stern look, the kind that says, "Don't make me tell you again." And they have their reasons, of course. They're the grown-ups in this scenario, armed with medical knowledge and a desire to keep you healthy.
But what actually happens if you… you know… accidentally have a sip? Or maybe a glass? Or, ahem, a whole evening of moderate merriment? This is where things get interesting, and perhaps a little less clear-cut than the official warnings suggest. It's a bit like asking if you can sneak a cookie when you're supposed to be on a diet. You probably can, but the consequences might not be as delightful as you imagine.
First off, let's talk about the general advice. Doctors often recommend avoiding alcohol when you're on antibiotics. Why? Well, it's a combination of factors. Alcohol can sometimes weaken your immune system. This isn't ideal when your body is already fighting a battle against bacteria. You want your immune system to be at its absolute A-game, not taking a nap.

Then there's the potential for increased side effects. Antibiotics, including Amoxicillin, can come with their own little party favors. Think nausea, upset stomach, or dizziness. Alcohol, on the other hand, can also cause these delightful symptoms. So, when you mix the two, you might be amplifying the "blah" factor. It's like adding fuel to an already smoldering fire of digestive distress.
However, here's where we venture into the realm of the "unpopular opinion" and some anecdotal evidence. For many people, a moderate amount of alcohol while taking Amoxicillin doesn't lead to a catastrophic health crisis. You might not spontaneously combust, nor will the antibiotic suddenly become a useless sugar pill. Your body is pretty resilient, and Amoxicillin is a pretty robust antibiotic.
Imagine this: you've had a rough day, you're recovering, and you decide to have one glass of wine. You're not chugging vodka like it's going out of style. In this scenario, the likelihood of a major negative interaction is relatively low. Your body is busy processing the medication and fighting off the germs. Adding a small amount of alcohol might just be a minor distraction for your liver.

The "What If" Scenarios
What if you have a little too much? This is where the fun police start to get involved. If you're drinking to excess, you're not just potentially interfering with your antibiotic. You're also dehydrating yourself, stressing your body, and potentially impairing your judgment about taking your medication on time. And let's not forget the hangover. A hangover on top of feeling under the weather? Nobody needs that.
Some people report that alcohol makes them feel more nauseous when on antibiotics. Others feel that it makes the antibiotic less effective. And then there are those who sail through their course of Amoxicillin with a nightly tipple and report no ill effects whatsoever. It's a bit of a choose-your-own-adventure, really.
My personal, entirely unscientific, and probably irresponsible experience? A glass of wine once in a while? No major drama. A full-blown pub crawl? Absolutely not. My stomach still remembers the last time I tried that during a penicillin-based adventure.
Can You Drink While on Amoxicillin? - Illinois Recovery Center
It's also important to remember that Amoxicillin isn't the only player in the game. Some antibiotics have a much more serious reaction with alcohol. For example, certain antibiotics can cause a severe, unpleasant reaction known as a "disulfiram-like reaction" when mixed with alcohol. This can lead to intense nausea, vomiting, facial flushing, and a rapid heart rate. Think of it as your body screaming, "NEVER AGAIN!" Amoxicillin isn't typically in this high-risk category, which is why the advice can feel a bit more nuanced.
The Nuance is Key
The "avoid alcohol" advice is often a blanket statement designed to cover all bases and err on the side of caution. It’s like telling everyone to wear a helmet while cycling – a good idea for most people, even if a professional racer might be able to get away with less. Your doctor is aiming for the safest possible outcome for the widest range of patients.
So, if you're contemplating a celebratory toast or a quiet nightcap, consider this: Is that drink really worth the potential discomfort? Could you perhaps postpone your indulgence until you've completed your course of Amoxicillin and your body is fully back to fighting form? The infection will be gone, and you can celebrate with a clear conscience and a fully functional digestive system.
However, if you do decide to have a small drink, and you're taking Amoxicillin, pay close attention to how you feel. If you experience any unusual or severe symptoms, it's always best to stop drinking and consult your doctor. They're there to help, even if you've dabbled in the forbidden fruit of alcohol while on medication.
Ultimately, the decision is yours. The official advice is to abstain. But if you're like many people and find yourself having a single, modest drink, the world is unlikely to end. Just don't go overboard. Your body is already working hard. Let's not add unnecessary stress to its already demanding schedule.
And when in doubt, always, always, always talk to your doctor or pharmacist. They have the real answers, even if they aren't as entertaining as the speculative theories floating around the internet. But between you and me, a little bit of cautious sipping probably won't send you into orbit. Just be smart about it.

